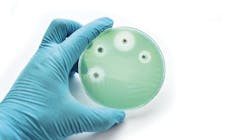
alternative to traditional antibiotics alternative to traditional antibiotics

Bacteriocins: A creative alternative to traditional antibiotics
When we think about creativity, the arts often come to mind. One area that is not top of mind, however, is science, but the creativity of researchers should be considered in the fight against periodontal disease. The lotions and potions we currently have may not be able to keep the oral microbiome as symbiotic as it should be. Creators at the bench are coming up with new ways to let nature help us help our patients.
Nature produces tiny antibiotics known as bacteriocins, which are bacterial peptides with potent antimicrobial properties. These endogenous proteins act as microscopic weapons that bacteria deploy to combat their rivals. They are highly targeted, focusing on specific bacterial strains to inhibit their growth or eliminate them entirely.
What makes bacteriocins exciting is their potential as alternatives to traditional antibiotics. Unlike broad-spectrum antibiotics that can harm beneficial bacteria, bacteriocins selectively target detrimental bacteria, preserving the delicate balance of the microbiome. Bacteriocins produced by friendly bacteria such as Streptococcus and Staphylococcus can help control periodontal pathogens like Porphyromonas gingivalis and Fusobacterium nucleatum.1-3 By innately controlling harmful bacteria, bacteriocins could be crucial in preventing and managing periodontal diseases without fostering resistance.
Lantibiotics, a unique subset of bacteriocins, are notable for their structural complexity. These peptides undergo extensive posttranslational modifications, incorporating unusual amino acids such as lanthionine and methyllanthionine.
Such modifications are vital as they enable the peptides to bind to and disrupt the cell walls of target bacteria, enhancing their antimicrobial effects. They can also inhibit bacterial growth, prevent biofilm formation, and modulate the immune system.
Ribosomally synthesized and posttranslationally modified peptides (RiPPs) represent a promising category of natural antimicrobial agents. Lantibiotics are enriched with these specialized amino acids through enzymatic processes, resulting in highly stable, bioactive compounds capable of effectively targeting and neutralizing specific bacterial strains. Lantibiotics hold significant potential as antimicrobial agents due to their low propensity for inducing resistance, making them highly appealing for medical applications.
Besides potentially replacing traditional antibiotics, lantibiotics could also be used as probiotics, preventive treatments, or additives. Scientists can use the natural enzyme systems that modify these peptides to create better synthetic versions or add stabilizing cross-links to other medications.
Therapeutic uses in dentistry
Among the various lantibiotics, salivaricin 10 (SALI-10), produced by Streptococcus salivarius, emerges as a promising candidate for therapeutic use in dentistry. S. salivarius, an early colonizer of the human oral cavity and gastrointestinal tract, produces RiPPs known as salivaricins, which are effective in inhibiting the growth of oral pathogens, including Porphyromonas gingivalis, Tannerella forsythia, and Neisseria gonorrhoeae.4
SALI-10 possesses structural differences compared to other lantibiotics because it’s phosphorylated, which means it is tagged with chemical compounds called phosphates. This plays an important role in the protein’s ability to induce enhanced immune responses. This immunomodulatory effect boosts neutrophil activity to engulf pathogens and encourage the development of anti-inflammatory M2 macrophages (immune cells that promote healing and regeneration of wounds) more efficiently and rapidly, reducing collateral damage to healthy tissues. These proteins target and disrupt bacterial biofilms, preventing the formation of harmful colonies.
This dual action of promoting immune function and inhibiting bacterial growth makes SALI-10 an innovative approach to targeting infectious pathogens while promoting a balanced oral microbiome. In the future, it could be incorporated into products such as probiotic lozenges, mouthwashes, toothpastes, dairy, and meat using its antimicrobial activity, or therapeutically in the treatment of infections caused by drug-resistant bacteria.
Thank you to Dr. Michael Glogauer, University of Toronto, for his valuable review of this article.
Editor's note: This article appeared in the March 2025 print edition of RDH magazine. Dental hygienists in North America are eligible for a complimentary print subscription. Sign up here.
References
- MacDonald KW, Chanyi RM, Macklaim JM, Cadieux PA, Reid G, Burton JP. Streptococcus salivarius inhibits immune activation by periodontal disease pathogens. BMC Oral Health. 2021;21(1):245. doi:10.1186/s12903-021-01606-z
- Castillo-Ruiz M, Daille LK, Machuca P, Bittner M. Antibacterial activity of a complex bacteriocin secreted by Staphylococcus epidermidis against Porphyromonas gingivalis. Arch Oral Biol. 2023;152:105730. doi:10.1016/j.archoralbio.2023.105730
- Wu C, Fujiki J, Mathieu J, Schwarz C, Cornell C, Alvarez PJJ. Phage-based biocontrol of Porphyromonas gingivalis through indirect targeting. Appl Environ Microbiol. 2024;90(10):e0095124. doi:10.1128/aem.00951-24
- Barbour A, Smith L, Oveisi M, et al. Discovery of phosphorylated lantibiotics with proimmune activity that regulate the oral microbiome. Proc Natl Acad Sci U S A. 2023;120(22):e2219392120. doi:10.1073/pnas.2219392120
About the Author

Anne O. Rice, BS, RDH, CDP, FAAOSH
Anne O. Rice, BS, RDH, CDP, FAAOSH, founded Oral Systemic Seminars after over 35 years of clinical practice and is passionate about educating the community on modifiable risk factors for dementia and their relationship to dentistry. She is a certified dementia practitioner, a longevity specialist, a fellow with AAOSH, and has consulted for Weill Cornell Alzheimer’s Prevention Clinic, FAU, and Atria Institute. Reach out to Anne at anneorice.com.